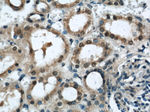
EIF4A3 Antibody in Immunohistochemistry (Paraffin) (IHC (P))

Search
Proteintech
EIF4A3 Polyclonal Antibody
{{$productOrderCtrl.translations['antibody.pdp.commerceCard.promotion.promotions']}}
{{$productOrderCtrl.translations['antibody.pdp.commerceCard.promotion.viewpromo']}}
{{$productOrderCtrl.translations['antibody.pdp.commerceCard.promotion.promocode']}}: {{promo.promoCode}} {{promo.promoTitle}} {{promo.promoDescription}}. {{$productOrderCtrl.translations['antibody.pdp.commerceCard.promotion.learnmore']}}
产品信息
17504-1-AP
种属反应
已发表种属
宿主/亚型
分类
类型
抗原
偶联物
形式
浓度
规格
纯化类型
保存液
内含物
保存条件
运输条件
产品详细信息
Immunogen sequence: MATTATMAT SGSARKRLLK EEDMTKVEFE TSEEVDVTPT FDTMGLREDL LRGIYAYGFE KPSAIQQRAI KQIIKGRDVI AQSQSGTGKT ATFSISVLQC LDIQVRETQA LILAPTRELA VQIQKGLLAL GDYMNVQCHA CIGGTNVGED IRKLDYGQHV VAGTPGRVFD MIRRRSLRTR AIKMLVLDEA DEMLNKGFKE QIYDVYRYLP PATQVVLISA TLPHEILEMT NKFMTDPIRI LVKRDELTLE GIKQFFVAVE REEWKFDTLC DLYDTLTITQ AVIFCNTKRK VDWLTEKMRE ANFTVSSMHG DMPQKERESI MKEFRSGASR VLISTDVWAR GLDVPQVSLI INYDLPNNRE LYIHRIGRSG RYGRKGVAIN FVKNDDIRIL RDIEQYYSTQ IDEMPMNVAD LI (1-411 aa encoded by BC003662)
靶标信息
eIF4A3 is a member of the DEAD box protein family. DEAD box proteins, characterized by the conserved motif Asp-Glu-Ala-Asp (DEAD), are putative RNA helicases. They are implicated in a number of cellular processes involving alteration of RNA secondary structure, such as translation initiation, nuclear and mitochondrial splicing, and ribosome and spliceosome assembly. Based on their distribution patterns, some members of this family are believed to be involved in embryogenesis, spermatogenesis, and cellular growth and division. eIF4A3 is a nuclear matrix protein. Its amino acid sequence is highly similar to the amino acid sequences of the translation initiation factors eIF4AI and eIF4AII, two other members of the DEAD box protein family.
仅用于科研。不用于诊断过程。未经明确授权不得转售。
生物信息学
蛋白别名: ATP-dependent RNA helicase DDX48; ATP-dependent RNA helicase eIF4A-3; DDX48; DEAD (Asp-Glu-Ala-Asp) box polypeptide 48; DEAD box protein 48; eIF-4A-III; Eukaryotic initiation factor 4A-III; Eukaryotic initiation factor 4A-like NUK-34; Eukaryotic translation initiation factor 4A isoform 3; eukaryotic translation initiation factor 4A, isoform 3; KIAA0111; NMP 265; Nuclear matrix protein 265; unnamed protein product
基因别名: 2400003O03Rik; DDX48; eIF-4A-III; eIF4A-III; EIF4A3; eIF4AIII; Fal1; KIAA0111; mKIAA0111; MUK34; NMP265; NUK34; RCPS
UniProt ID: (Human) P38919, (Mouse) Q91VC3, (Rat) Q3B8Q2
Entrez Gene ID: (Human) 9775, (Mouse) 192170, (Rat) 688288